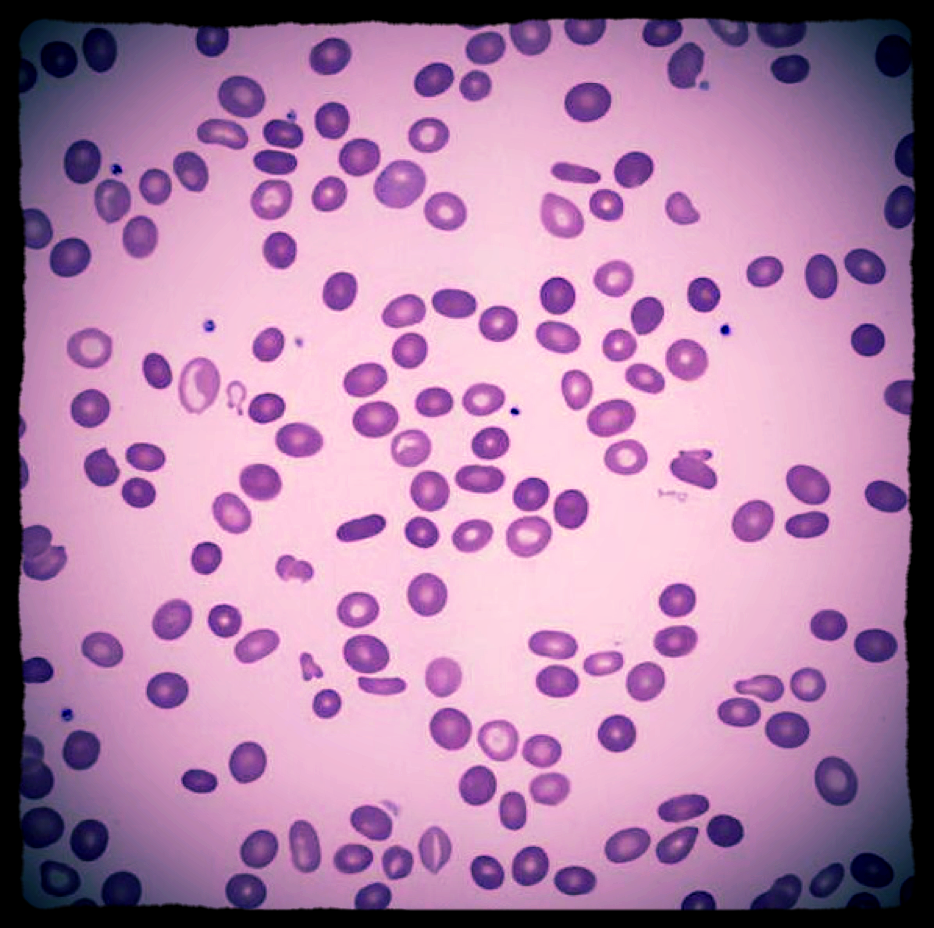

Our lab is focused on understanding the genetic changes that drive the development and progression of hematologic malignancies like acute myeloid leukemia and myelodysplastic syndromes. Our goal is to translate our discoveries into clinically meaningful improvements in how we care for patients with these disorders.
Anatomy of the bone.The bone is made up of compact bone, spongy bone, and bone marrow. Compact bone makes up the outer layer of the bone. Spongy bone is found mostly at the ends of bones and contains red marrow. Bone marrow is found in the center of most bones and has many blood vessels. There are two types of bone marrow: red and yellow. Red marrow contains blood stem cells that can become red blood cells, white blood cells, or platelets. Yellow marrow is made mostly of fat.
Blood cell development. A blood stem cell goes through several steps to become a red blood cell, platelet, or white blood cell.
Our prior work helped characterize the range of genetic alterations that exist in patients with myelodysplastic syndromes (MDS). We studied bone marrow sample from over 400 patients with these disorders and examined them for mutations in over 20 recurrently mutated genes. We learned about the relative frequency of these mutations, how they can overlap with each other, and how they may better classify molecular subtypes of MDS. We demonstrated that mutations in several genes are associated with clinical features seen in patients with MDS, potentially explaining much of the heterogeneity associated with this disease. Most importantly, we identified mutations in several genes, that when present, are associated with a poorer prognosis than would otherwise be predicted using standard clinical scoring systems. This has helped accelerate the drive to include tumor sequencing in the standard evaluation of patients with MDS
Distribution of recurrent mutations and karyotypic abnormalities in MDS - Bejar et al 2015 (click on the image to enlarge)
Currently we are investigating how acquired mutations in the diseased cells from patients with myelodysplastic syndromes are associated with their response to treatment with drugs like azacitidine and decitabine. We hope to discover genes that physicians can test for mutations in order to select the best treatment options for their patients with MDS. These studies should also give us insight into the mechanisms of drug resistance and how we may be able to overcome them.
Read Dr. Bejar's interview in the Josep Carreras Leukemia Research Institute (in Spanish)
11th Moores Cancer Center Industry/Academia Translational Oncology Symposium February 19, 2015 Advancing the Utility of Clinic Sequencing for MDS Rafael Bejar, MD, PhD UC San Diego Moores Cancer Center Visit our symposium website at moores.ucsd.edu/industryrelations/symposium.html for more featured videos.